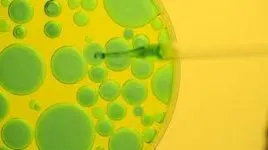
labpetri

Mold Inspection and Remediation Process | Experience and Industry Standards Guide
Mold Testing San Francisco
Mold Inspection and Remediation Process
| 1. Air Sample Testing:s | 2. Moisture Inspection: |
| 3. Review of Findings and Estimate: | 4. Mold Cleanup and Containment: |
| 5. Post-remediation Review air sample testing: |
Our Process:
1. Air Sample Testing:
With industry-standard equipment, our team can perform room-to-room inspections to measure just how far the mold is spreading. This allows us to precisely locate and isolate each area where spores are present.
2. Moisture Inspection:
Mold almost always comes with a number of other issues, namely moisture and water damage. Part of our inspection process includes a thorough moisture inspection that identifies what areas are damp, how much moisture is present and what the causes are.
3. Review of Findings and Estimate:
After performing an on-site inspection of the mold and moisture, we will analyze our findings to determine the best course of action. We will review every step involved and then give you an estimate on what needs to be done, how long it will take and how much it will cost.
4. Mold Cleanup and Containment:
Based on the analysis of the information received from air tests and moisture inspections, we’ll conduct thorough mold remediation procedures, being sure to address all areas.
5. Post-remediation Review air sample testing to verify effectiveness of cleaning:
Making sure all mold is thoroughly eliminated often requires a follow-up inspection. Lingering spores commonly cause regrowth throughout the building. Post-remediation ensures the problem has been addressed entirely.
Mold is a common problem in homes and other buildings, and it’s one that shouldn’t be left alone. Identifying mold, however, can be somewhat difficult for many home- and business owners. Some mistakenly assume the characteristic damp smell of mold is nothing more than a common “basement stench.” Even when it’s known that mold is present, finding and isolating it is a task too great for most.
Mold is notorious for spreading throughout a building quite easily—especially when there’s an HVAC system present. Spores can travel through the air, landing and growing in other moist areas such as kitchens and bathrooms.
Mold Clean Up Experience
Experience and Industry Standards Guide Our Approach to Mold Remediation.
At Allied Restoration Company, we take mold growth seriously. That’s why our team of remediation experts is trained and capable of per
forming industry-standard protocols. We make sure that when the job completes, all mold is gone and is extremely unlikely to return.
Experts in the identification and removal of mold infestation, we use state of the art methods and equipment to accomplish the task and were here when you need us.
If you are in the process of buying a new house, are a tenant concerned about air quality, a landlord, property manager or real estate agent, we can help. Clients throughout San Francisco have relied on our services for unparalleled results—and at a competitive price.
Our proven method
We advise all home- and business owners to test for high levels of mold and moisture, get an estimate to clean it up and verify that the air quality has improved. The longer a problem goes unaddressed, the worse it can become. Mold spreads easily, but timely response will ensure a clean and safe area.
Give us a call at 415-529-5637.





